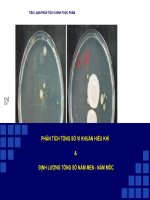
PHÂN TÍCH TỔNG SỐ VI KHUẨN HIẾU KHÍ - ĐỊNH LƯỢNG TỔNG SỐ NẤM MEN-NẤM MÔC

- Trang chủ >>
- Y - Dược >>
- Vi sinh học
NẤM MỐC ( Molds)
Bạn đang xem bản rút gọn của tài liệu. Xem và tải ngay bản đầy đủ của tài liệu tại đây (8.69 MB, 139 trang )
Nấm mốc ( Molds)
Nấm mốc hay nấm sợi là những nấm mọc trên thực
phẩm, chiếu , quần áo, giầy dép… Nhiều nấm ký sinh trên
người, động vật, thực vật gây ra các bệnh nấm khá nguy
hiểm.
Trong tự nhiên nấm mốc phân bố rộng rải và tham gia
tích cực vào vòng tuần hoàn vật chất.
Nhiều loài nấm được sử dụng trong công nghiệp chế biến
thực phẩm (làm tương , chao,nước chấm)trong công
nghiệp (sản xuất amlase, proteiase,cellullase,
pectinase…)trong dược phẩm (sản xuất kháng sinh, các
steroid…). Nấm được sử dụng để xử lý ô nhiễm môi
trường.
VỊ TRÍ VÀ VAI TRÒ CỦA NẤM MỐC
Nấm mốc có ảnh hưởng xấu đến cuộc sống con người một cách trực tiếp bằng cách
làm hư hỏng, giảm phẩm chất lương thực, thực phẩm trước và sau thu hoạch,
trongchế biến, bảo quản. Nấm mốc còn gây hư hại vật dụng, quần áo... hay gây
bệnh cho người, động vật khác và cây trồng. Tuy nhiên, các qui trình chế biến thực
phẩm có liên quan đến lên men đều cần đến sự có mặt của vi sinh vật trong đó có
nấm mốc. Nấm mốc cũng giúp tổng hợp những loại kháng sinh (penicillin,
griseofulvin), acit hữu cơ (acit oxalic, citric, gluconic...), vitamin (nhóm B,
riboflavin), kích thích tố (gibberellin, auxin, cytokinin), một số enzim và các hoạt
chất khác dùng trong công nghiệp thực phẩm và y, dược ... đã được sử dụng rộng
rãi trên thế giới. Ngoài ra, nấm còn giử vai trò quan trọng trong việc phân giải chất
hữu cơ trả lại độ mầu mỡ cho đất trồng.
Một số loài thuộc giống Rhizopus, Mucor, Candida gây bệnh trên người,
Microsporum gây bệnh trên chó, Aspergillus fumigatus gây bệnh trên chim;
Saprolegnia và Achlya gây bệnh nấm ký sinh trên cá. Những loài nấm gây bệnh
trên cây trồng như Phytophthora, Fusarium, Cercospora.... đặc biệt nấm Aspergilus
flavus và Aspergillus fumigatus phát triển trên ngũ cốc trong điều kiện thuận lợi
sinh ra độc tố aflatoxin.
Bên cạnh tác động gây hại, một số loài nấm mốc rất hữu ích trong sản xuất và đời
sống như nấm ăn, nấm dược phẩm (nấm linh chi, Penicillium notatum tổng hợp nên
penicillin, Penicillium griseofulvum tổng hợp nên griseofulvin...), nấm Aspergillus
niger tổng hợp các acit hữu cơ như acit citric, acit gluconic, nấm Gibberella
fujikuroi tổng hợp kích thích tố gibberellin và một số loài nấm thuộc nhóm
Phycomycetina hay Deuteromycetina có thể ký sinh trên côn trùng gây hại qua đó
có thể dùng làm thiên địch diệt côn trùng. Ngoài ra, những loài nấm sống cộng sinh
với thực vật như Nấm rễ (Mycorrhizae), giúp cho rễ cây hút được nhiều hơn lượng
phân vô cơ khó tan và cung cấp cho nhu cầu phát triển của cây trồng.
Nấm còn là đối tượng nghiên cứu về di truyền học như nấm Neurospora crassa,
nấm Physarum polycephalum dùng để tổng hợp ADN và những nghiên cứu khác.
Nấm học (Mycology) được khai sinh bỡi nhà thực vật
học người Ý tên là Pier Antonio Micheli (1729) qua tài
liệu công bố “giống cây lạ” (Nova Plantarum Genera).
Nấm mốc có khoảng 5.100 giống và 50.000 loài được
mô tả, tuy nhiên, ước tính có trên 100.000 đến
250.000 loài nấm hiện diện trên trái đất
Là vi sinh vật chân hạch,thuộc ngành
nấm(Euphycophyta), ở thể tản (thalophyte).
Tế bào không có diệp lục tố, sống dị dưỡng (hoại sinh,
ký sinh, cộng sinh), vách tế bào cấu tạo chủ yếu là
chitin, có hay không có celluloz và một số thành phần
khác có hàm lượng thấp.‘
Nhiều loài nấm mốc có khả năng ký sinh trên nhiều ký
chủ như động vật, thực vật, đặc biệt trên con người,
cây trồng, vật nuôi, sản phẩm sau thu hoạch chưa hoặc
đã qua chế biến, bảo quản. Một số là tác nhân gây
bệnh, làm hư các thiết bị thủy tinh bảo quản không tốt
nhưng cũng có nhiều loài có ích như tổng hợp ra acit
hữu cơ, thuốc kháng sinh, vitamin, kích thích tố tăng
trưởng thực vật đã được đưa vào sản xuất công nghiệp
và có một số nấm được dùng làm đối tượng nghiên cứu
về di truyền học.
Tên khoa học: Beauveria bassiana
Họ: Moniliaceae
Bộ: Moniliales
Châu chấu bị giết bởi nấm Beauveria bassiana
Điều khiển sinh học là thuật ngữ đề cập đến khả năng
diệt trừ sâu hại của nấm
Nấm rất tích cực trong cạnh tranh về dinh dưỡng và không gian
với những sinh vật khác, thông qua định luật Gause (nguyên tắc
ức chế cạnh tranh), và điều này đôi khi có lợi cho con người. Ví
dụ, nấm có thể ngăn chặn sự tăng trưởng hay loại trừ kẻ thù
nguy hiểm của thực vật và con người, như kiến đục gỗ, mối, châu
chấu, muỗi, ve bét, cỏ dại, giun tròn hay nấm khác mà có thể gây
hại cho mùa màng và nhà cửa. Khả năng điều khiển sinh học các
loài gây hại cho nông nghiệp của nấm đã được quan tâm và ứng
dụng thực tế. Loài nấm kí sinh côn trùng đã được sử dụng làm
thuốc trừ sâu sinh học vì khả năng kí sinh và tiêu diệt côn trùng
của chúng. Một số ví dụ về những nấm loại này là Beauveria
bassiana, Metarhizium anisopliae, chi Hirsutella, chi Paecilomyces
và Verticillium lecanii. Nấm gây bệnh côn trùng đã phát hiện được
750 lòai, nhiều hơn động vật có xương sống ( 200 loài ), và ít hơn
nấm gây bệnh thực vật ( 1300 loài ).. Có ít nhất 14 loại nấm có
khả năng chống rệp. Loài nấm thuộc chi Trichoderma cũng có khả
năng ngăn chặn những loài nấm gây bệnh cho cây
Hình thái và cấu trúc nấm mốc
Nấm mốc có cấu tạo sợi đa bào gọi là khuẩn ty.
Khuẩn ty không có vách ngăn hay có vách ngăn.
Khuẩn ty chỉ sinh trưỡng ở ngọn.
Có 2 loại khuẩn ty:
*Khuẩn ty cơ chất : chức năng dinh dưỡng
*Khuẩn ty khí sinh: chức năng sinh sản và hấp
thu dưỡng khí.
Ở nấm kí sinh khuẩn ty có thể biến hoá hình
dạng để đãm nhận chức năng dinh dưỡng hay bảo
vệ
Sợi nấm thường là một ống hình trụ dài có kích
thước lớn nhỏ khác nhau tùy loài. Đường kính của
sợi nấm thường từ 3-5µm, có khi đến 10µm, thậm
chí đến 1mm. Chiều dài của sợi nấm có thể tới vài
chục centimet. Các sợi nấm phát triển chiều dài
theo kiểu tăng trưởng ở ngọn (Hình 1.).
Các sợi nấm có thể phân nhánh và các nhánh có
thể lại phân nhánh liên tiếp tạo thành hệ sợi nấm
(mycelium) khí sinh xù xì như bông.
Trên môi trường đặc và trên một số cơ chất trong
tự nhiên, bào tử nấm, tế bào nấm hoặc một đoạn
sợi nấm có thể phát triển thành một hệ sợi nấm có
hình dạng nhất định gọi là khuẩn lạc nấm (Hình
1.2)
Có 2 loại sợi nấm:
Dạng sợi nấm có vách ngăn-cơ cấu tế bào
Dạng sợi nấm không có vách ngăn-cơ cấu cộng
bào.
Khuẩn ty có vách ngăn và
không vách ngăn
Khuaån ty cuûa naám moác
Khuaån ty cuûa naám moác
Khuaån ty cuûa naám moác
Khuaån ty khí sinh vaø khuaån ty cô chaát
Các dạng biến hoá của khuẩn ty
Sợi áp : phần nấm tiếp
xúc với vật chủ sẽ phình
to, tăng diện tích tiếp xúc
với vật chủ. Phần này
thường có hình dóa, có
nhiều nhân, áp chặt vào
vật chủ. Các mô của vật
chủ dưới tác động cua
enzime do nấm tiêt ra sẽ
bò phá huỷ từng phần hay
hoàn toàn..
haustorium: (pl. haustoria)
specialized branch of a parasite
formed inside host cells to absorb
nutrients
2. Sợi hút :
Gặp ở nấm ký sinh,
chúng mọc các khuẩn
ti và phân nhánh đâm
sâu vào tế bào chủ, ở
đó chúng biến thành
hình cầu, hình ngón
tay, hình sợi. Chúng
sử dụng sợi hút để hút
chất dinh dữong tử cơ
thể vật chủ.
•1. Rể giả: trông
gần giống như
chùm rể phân
nhánh có tác dụng
giúp nấm bám chặt
vào cơ chất và hấp
thu dưỡng liệu. EX:
Nấm Rhizopus..
Naám baåy moài
Sợi hút
4.Sợi thòng lọng:
Sợi nấm dạng thòng lọng có khuyên tròn
dọc sợi nấm . Mỗi khuyên gồm 3 tế bào
xếp nối tiếp nhau và nối vào sợi nấm chính
bằng một đọan ngắn. Khi mặt trong của 3
tế bào khuyên này tiếp xúc với con mồi thì
lập tức cac không bào sẽ phồng to ra và
căng mạnh vào phía trong, thắt chặt con
mồi lại. Sau đó mọc ra các nhánh xuyên
sâu vào cơ thể con mồi và tiếp tục phát
sinh ra các sợi hút.